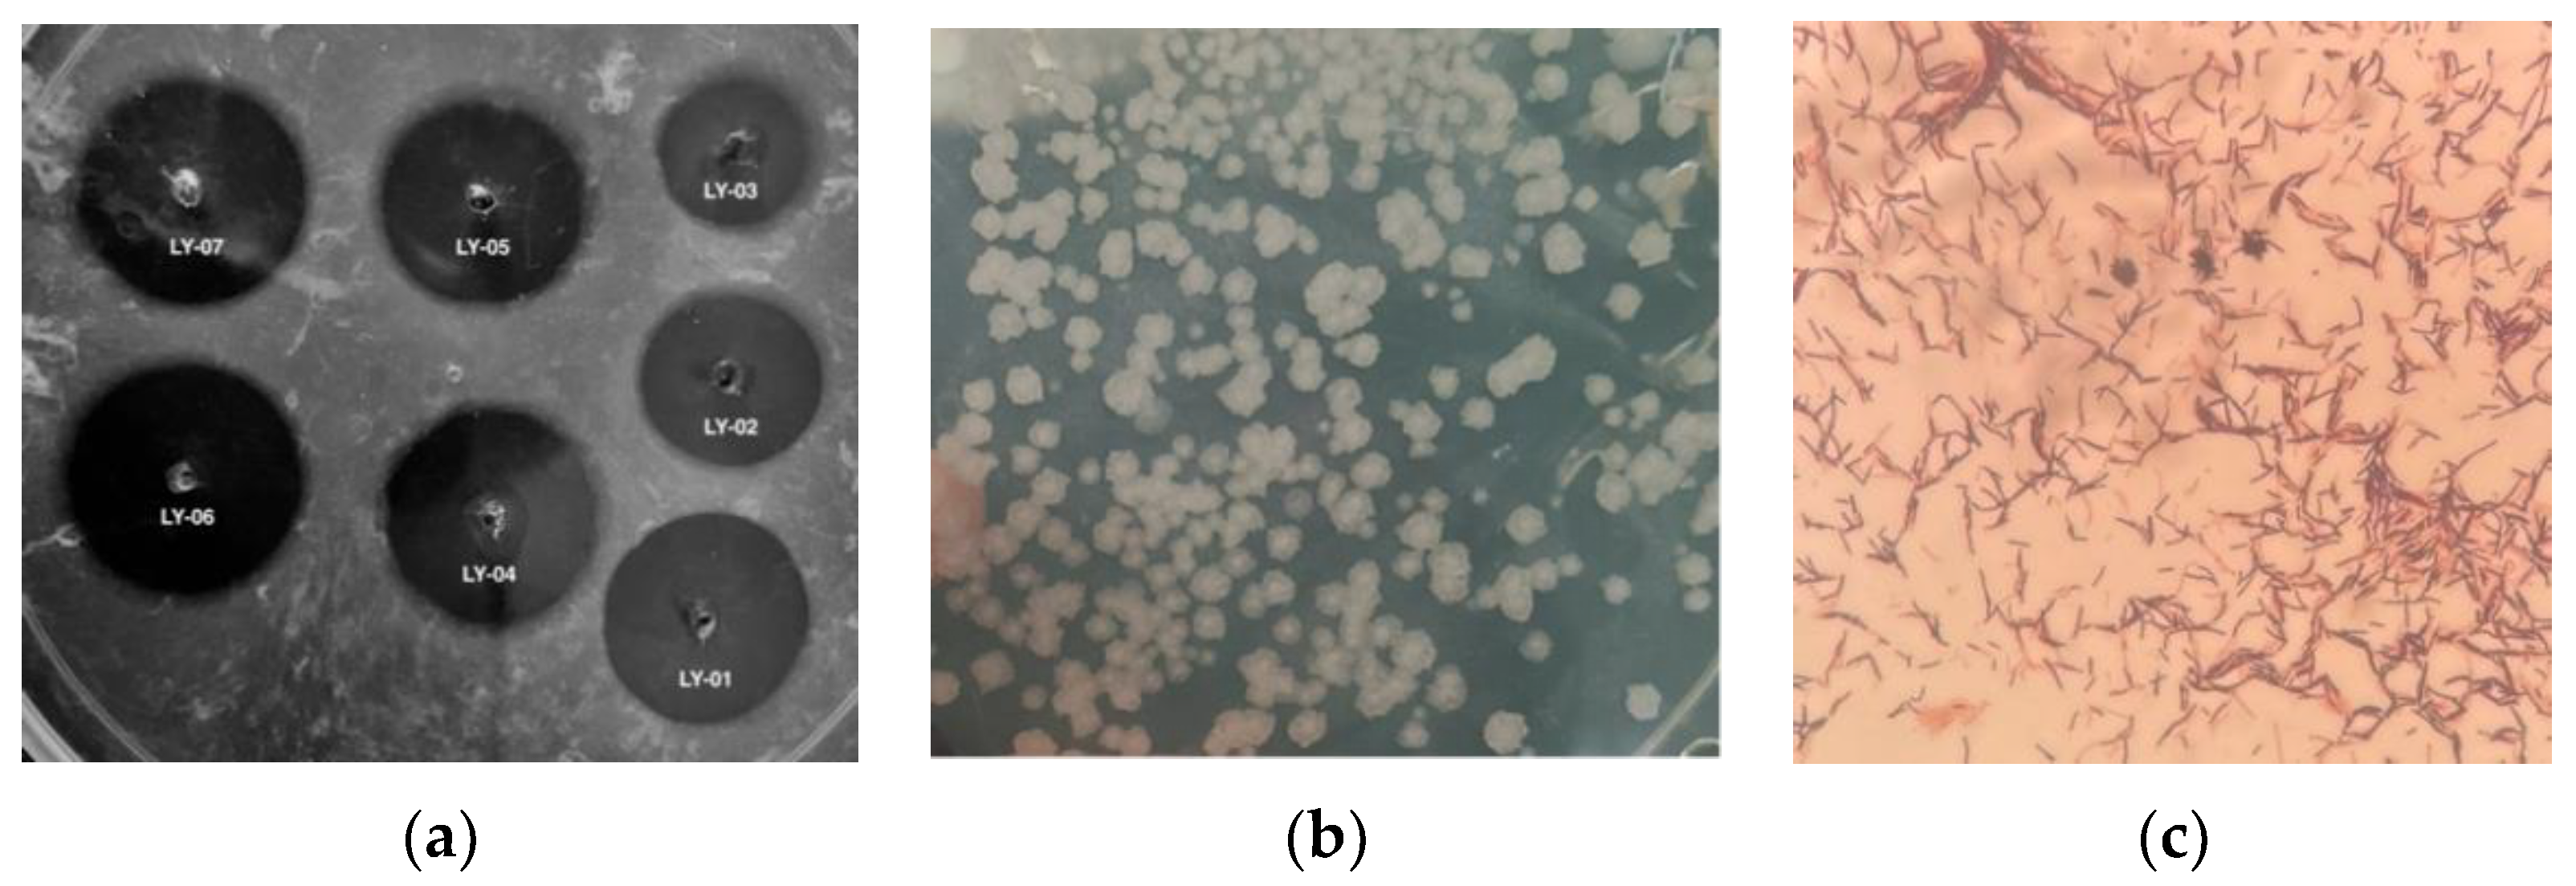
Foods 11 02403 g001

Characterization of a Nattokinase from the Newly Isolated Bile Salt-Resistant Bacillus mojavensis LY-06
Abstract
:1. Introduction
2. Materials and Methods
2.1. Samples, Plasmids, and Chemicals
2.2. Assay of Fibrinolytic Activity
2.3. Isolation of Strains Producing Nattokinase
2.4. Identification of Strains Producing Nattokinase
2.5. Stress Tolerance Detection of Isolated Bacillus mojavensis LY-06 Strain
2.6. Growth Curve Determination of Bacillus mojavensis LY-06 Strain
2.7. Optimization of the Fermentation Process of AprY Production
2.8. Construction of the Expression Plasmids Encoding aprY in Escherichia coli
2.9. Bacterial Expression and Purification of rAprY
2.10. Biochemical Characterization of AprY and rAprY
2.11. Bioinformatics Analysis
2.12. Productivity Curves of AprY and rAprY
2.13. Statistical Analyses
3. Results
3.1. Screening and Identification of Bile Salt-Tolerant and High-Yielding Nattokinase Strains
3.2. Stress Tolerance Detection and Growth Curve of Bacillus mojavensis LY-06 Strain
3.3. Regulation of Nattokinase Production by Carbon and Nitrogen Sources
3.4. Regulation of Nattokinase Production with Inorganic Salt
3.5. Effect of Orthogonal Array Design of Nutrient Optimization on Nattokinase Production
3.6. Cloning, Expression, and Purification of rAprY
3.7. Biochemical Characterization and Productivity Curves of AprY and rAprY (C-Terminal Contains His-Tag)
4. Conclusions
Author Contributions
Funding
Data Availability Statement
Conflicts of Interest
References
- Kotb, E. The biotechnological potential of fibrinolytic enzymes in the dissolution of endogenous blood thrombi. Biotechnol. Prog. 2014, 30, 656–672. [Google Scholar] [CrossRef] [PubMed]
- Gianforcaro, A.; Kurz, M.; Guyette, F.; Callaway, C.W.; Rittenberger, J.C.; Elmer, J. Association of antiplatelet therapy with patient outcomes after out-of-hospital cardiac arrest. Resuscitation 2017, 121, 98–103. [Google Scholar] [CrossRef]
- Furie, B.; Furie, B.C. Mechanisms of thrombus formation. N. Engl. J. Med. 2008, 359, 938–949. [Google Scholar] [CrossRef] [PubMed]
- Sumi, H.; Hamada, H.; Tsushima, H.; Mihara, H.; Muraki, H. A novel fibrinolytic enzyme (nattokinase) in the vegetable cheese Natto; a typical and popular soybean food in the Japanese diet. Experientia 1987, 43, 1110. [Google Scholar] [CrossRef] [PubMed]
- Ren, N.; Chen, H.J.; Li, Y.; Mcgowan, G.W.; Lin, Y.G. A clinical study on the effect of nattokinase on carotid artery atherosclerosis and hyperlipidaemia. Zhonghua Yi Xue Za Zhi 2017, 97, 2038–2042. [Google Scholar] [PubMed]
- Dabbagh, F.; Negahdaripour, M.; Berenjian, A.; Behfar, A.; Mohammadi, F.; Zamani, M.; Irajie, C.; Ghasemi, Y. Nattokinase: Production and application. Appl. Microbiol. Biotechnol. 2014, 98, 9199–9206. [Google Scholar] [CrossRef]
- Zhang, X.; Lyu, X.; Tong, Y.; Wang, J.; Ye, J.; Yang, R. Chitosan/casein based microparticles with a bilayer shell–core structure for oral delivery of nattokinase. Food Funct. 2020, 11, 10799–10816. [Google Scholar] [CrossRef]
- Sumi, H.; Nakajima, N.; Taya, N. The Method of Determination of the Thrombolytic Enzyme Nattokinase. J. Brew. Soc. Jpn. 1993, 88, 482–486. [Google Scholar] [CrossRef] [Green Version]
- Yatagai, C.; Maruyama, M.; Kawahara, T.; Sumi, H. Nattokinase-promoted tissue plasminogen activator release from human cells. Pathophysiol. Haemost. Thromb. 2008, 36, 227–232. [Google Scholar] [CrossRef]
- Urano, T.; Ihara, H.; Umemura, K.; Suzuki, Y.; Oike, M.; Akita, S.; Tsukamoto, Y.; Suzuki, I.; Takada, A. The Profibrinolytic Enzyme Subtilisin NAT Purified from Bacillus subtilis Cleaves and Inactivates Plasminogen Activator Inhibitor Type 1. J. Biol. Chem. 2001, 276, 24690–24696. [Google Scholar] [CrossRef] [Green Version]
- Hsia, C.-H.; Shen, M.C.; Lin, J.S.; Wen, Y.K.; Hwang, K.L.; Cham, T.M.; Yang, N.C. Nattokinase decreases plasma levels of fibrinogen, factor VII, and factor VIII in human subjects. Nutr. Res. 2009, 29, 190–196. [Google Scholar] [CrossRef] [PubMed]
- Jang, J.Y.; Kim, T.S.; Cai, J.; Kim, J.; Kim, Y.; Shin, K.; Kim, Y.B. Nattokinase improves blood flow by inhibiting platelet aggregation and thrombus formation. Lab. Anim. Res. 2013, 29, 221–225. [Google Scholar] [CrossRef]
- Wu, H.; Wang, Y.; Zhang, Y.; Xua, F.; Chen, J.; Duan, L.; Zhang, T.; Wang, J.; Zhang, F. Breaking the vicious loop between inflammation, oxidative stress and coagulation, a novel anti-thrombus insight of nattokinase by inhibiting LPS-induced inflammation and oxidative stress. Redox Biol. 2020, 32, 101500. [Google Scholar] [CrossRef] [PubMed]
- Guo, H.; Ban, Y.-H.; Cha, Y.; An, E.S.; Choi, J.; Seo, D.W.; Park, D.; Choi, E.-K.; Kim, Y.-B. Comparative anti-thrombotic activity and haemorrhagic adverse effect of nattokinase and tissue-type plasminogen activator. Food Sci. Biotechnol. 2019, 28, 1535–1542. [Google Scholar] [CrossRef]
- Wu, H.; Wang, H.; Xu, F.; Chen, J.; Duan, L.; Zhang, F. Acute toxicity and genotoxicity evaluations of Nattokinase, a promising agent for cardiovascular diseases prevention. Regul. Toxicol. Pharm. 2019, 103, 205–209. [Google Scholar] [CrossRef] [PubMed]
- Pan, S.; Chen, G.; Zeng, J.; Cao, X.; Zheng, X.; Zeng, W.; Liang, Z. Fibrinolytic enzyme production from low-cost substrates by marine Bacillus subtilis: Process optimization and kinetic modeling. Biochem. Eng. J. 2019, 141, 268–277. [Google Scholar] [CrossRef]
- Devi, C.S.; Mohanasrinivasan, V.; Sharma, P.; Das, D.; Vaishnavi, B.; Naine, S.J. Production, Purification and Stability Studies on Nattokinase: A Therapeutic Protein Extracted from Mutant Pseudomonas aeruginosa CMSS Isolated from Bovine Milk. Int. J. Pept. Res. Ther. 2015, 22, 263–269. [Google Scholar] [CrossRef]
- Wang, S.H.; Zhang, C.; Yang, Y.L.; Diao, M.; Bai, M.F. Screening of a high fibrinolytic enzyme producing strain and characterization of the fibrinolytic enzyme produced from Bacillus subtilis LD-8547. World J. Microbiol. Biotechnol. 2007, 24, 475–482. [Google Scholar] [CrossRef]
- Zhang, X.; Tong, Y.; Wang, J.; Lyu, X.; Yang, R. Screening of a Bacillus subtilis strain producing both nattokinase and milk-clotting enzyme and its application in fermented milk with thrombolytic activity. J. Dairy Sci. 2021, 104, 9437–9449. [Google Scholar] [CrossRef]
- Wei, X.; Luo, M.; Xu, L.; Zhang, Y.; Lin, X.; Kong, P.; Liu, H. Production of fibrinolytic enzyme from Bacillus amyloliquefaciens by fermentation of chickpeas, with the evaluation of the anticoagulant and antioxidant properties of chickpeas. J. Agric. Food Chem. 2011, 59, 3957–3963. [Google Scholar] [CrossRef]
- Park, C.-S.; Kim, D.K.; Lee, W.-Y.; Kang, D.-O.; Song, J.J.; Choi, N.-S. Identification of fibrinogen-induced nattokinase WRL101 from Bacillus subtilis WRL101 isolated from Doenjang. Afr. J. Microbiol. Res. 2013, 7, 1983–1992. [Google Scholar]
- Saidumohamed, B.E.; Bhat, S.G. Indian oil sardine (Sardinella longiceps) gut derived Bacillus safensis SDG14 with enhanced probiotic competence for food and feed applications. Food Res. Int. 2021, 150, 110475. [Google Scholar] [CrossRef] [PubMed]
- Li, M.; Zhang, Z.; Li, S.; Tian, Z.; Ma, X. Study on the mechanism of production of gamma-PGA and nattokinase in Bacillus subtilis natto based on RNA-seq analysis. Microb. Cell Fact. 2021, 20, 83. [Google Scholar] [CrossRef] [PubMed]
- Wei, X.; Luo, M.; Xie, Y.; Yang, L.; Li, H.; Xu, L.; Liu, H. Strain screening, fermentation, separation, and encapsulation for production of nattokinase functional food. Appl. Biochem. Biotechnol. 2012, 168, 1753–1764. [Google Scholar] [CrossRef]
- Xiao, Z.; Shen, J.; Li, Y.; Wang, Z.; Zhao, Y.; Chen, Y.; Zhao, J.-Y. High and Economical Nattokinase Production with Acetoin as a Useful Byproduct from Soybean Milk and Glucose. Probiotics Antimicrob. Proteins 2021, 1–12. [Google Scholar] [CrossRef]
- Li, T.; Zhan, C.; Guo, G.; Liu, Z.; Hao, N.; Ouyang, P. Tofu processing wastewater as a low-cost substrate for high activity nattokinase production using Bacillus subtilis. BMC Biotechnol. 2021, 21, 57. [Google Scholar] [CrossRef]
- Ni, H.; Guo, P.-C.; Jiang, W.-L.; Fan, X.-M.; Luo, X.-Y.; Li, H.-H. Expression of nattokinase in Escherichia coli and renaturation of its inclusion body. J. Biotechnol. 2016, 231, 65–71. [Google Scholar] [CrossRef]
- Liang, X.; Zhang, L.; Zhong, J.; Huan, L. Secretory expression of a heterologous nattokinase in Lactococcus lactis. Appl. Microbiol. Biotechnol. 2007, 75, 95–101. [Google Scholar] [CrossRef]
- Nguyen, T.T.; Quyen, T.D.; Le, H.T. Cloning and enhancing production of a detergent-and organic-solvent-resistant nattokinase from Bacillus subtilis VTCC-DVN-12-01 by using an eight-protease-gene-deficient Bacillus subtilis WB800. Microb. Cell Fact. 2013, 12, 1–11. [Google Scholar] [CrossRef] [Green Version]
- Guangbo, Y.; Min, S.; Wei, S.; Lixin, M.; Chao, Z.; Yaping, W.; Zunxi, H. Heterologous expression of nattokinase from B. subtilis natto using Pichia pastoris GS115 and assessment of its thrombolytic activity. BMC Biotechnol. 2021, 21, 49. [Google Scholar] [CrossRef]
- Li, C.; Du, Z.; Qi, S.; Zhang, X.; Wang, M.; Zhou, Y.; Lu, H.; Gu, X.; Tian, H. Food-grade expression of nattokinase in Lactobacillus delbrueckii subsp. bulgaricus and its thrombolytic activity in vitro. Biotechnol. Lett. 2020, 42, 2179–2187. [Google Scholar] [CrossRef] [PubMed]
- Chen, H.; Chao, Y.-P.; Tzen, J.T.C. Efficient System of Artificial Oil Bodies for Functional Expression and Purification of Recombinant Nattokinase in Escherichia coli. J. Agric. Food Chem. 2005, 53, 4799–4804. [Google Scholar]
- Yuan, L.; Liangqi, C.; Xiyu, T.; Jinyao, L. Biotechnology, Bioengineering and Applications of. Biomolecules 2022, 12, 980. [Google Scholar] [CrossRef] [PubMed]
- Astrup, T.; Müllertz, S. The fibrin plate method for estimating fibrinolytic activity. Arch. Biochem. Biophys. 1952, 40, 346–351. [Google Scholar] [CrossRef]
- Song, C.W.; Rathnasingh, C.; Park, J.M.; Lee, J.; Song, H. Isolation and Evaluation of Bacillus Strains for Industrial Production of 2,3-Butanediol. J. Microbiol. Biotechnol. 2018, 28, 409–417. [Google Scholar] [CrossRef] [PubMed] [Green Version]
- Wang, C.; Du, M.; Zheng, D.; Kong, F.; Zu, G.; Feng, Y. Purification and Characterization of Nattokinase from Bacillus subtilis Natto B-12. J. Agric. Food Chem. 2009, 57, 9722–9729. [Google Scholar] [CrossRef] [PubMed]
- Wei, R.; Liu, Z.; Wen, J. Determination of extracellular fibrinolytic activity of nattokinase by ultraviolet spectrophotometry. China Brew. 2012, 1, 184–188. [Google Scholar]
- Zheng, W.; Zhang, C.; Li, Y.; Pearce, R.; Bell, E.W.; Zhang, Y. Folding non-homologous proteins by coupling deep-learning contact maps with I-TASSER assembly simulations. Cell Rep. Methods 2021, 1, 100014. [Google Scholar] [CrossRef]
- Sarakatsannis, J.N.; Duan, Y. Statistical characterization of salt bridges in proteins. Proteins Struct. Funct. Bioinform. 2005, 60, 732–739. [Google Scholar] [CrossRef]
- Kabsch, W.; Sander, C. Dictionary of protein secondary structure: Pattern recognition of hydrogen-bonded and geometrical features. Biopolymers 1983, 22, 2577–2637. [Google Scholar] [CrossRef]
- Jochens, H.; Hesseler, M.; Stiba, K.; Padhi, S.K.; Kazlauskas, R.J.; Bornscheuer, U.T. Protein engineering of α/β-hydrolase fold enzymes. Chembiochem 2011, 12, 1508–1517. [Google Scholar] [CrossRef] [PubMed]
- Jeżewska-Frąckowiak, J.; Seroczyńska, K.; Banaszczyk, J.; Woźniak, D.; Żylicz-Stachula, A.; Skowron, P.M. The promises and risks of probiotic Bacillus species. Acta Biochim. Pol. 2018, 65, 509–519. [Google Scholar] [CrossRef] [PubMed] [Green Version]
- Kumar, D.M.; Rakshitha, R.; Vidhya, M.A.; Jennifer, P.S.; Prasad, S.; Kumar, M.R.; Kalaichelv, P. Production, Optimization and Characterization of Fibrinolytic Enzyme by Bacillus subtilis RJAS19. Pak. J. Biol. Sci. 2014, 17, 529–534. [Google Scholar] [CrossRef] [PubMed] [Green Version]
- Man, L.-L.; Xiang, D.-J.; Zhang, C.-L. Strain Screening from Traditional Fermented Soybean Foods and Induction of Nattokinase Production in Bacillus subtilis MX-6. Probiotics Antimicrob. Proteins 2018, 11, 283–294. [Google Scholar]
- Wang, C.T.; Ji, B.P.; Li, B.; Nout, R.; Li, P.L.; Ji, H.; Chen, L.F. Purification and characterization of a fibrinolytic enzyme of Bacillus subtilis DC33, isolated from Chinese traditional Douchi. J. Ind. Microbiol. Biotechnol. 2006, 33, 750–758. [Google Scholar] [CrossRef]
- Berenjian, A.; Mahanama, R.; Kavanagh, J.; Dehghani, F.; Ghasemi, Y. Nattokinase production: Medium components and feeding strategy studies. Chem. Ind. Chem. Eng. Q. 2014, 20, 541–547. [Google Scholar] [CrossRef]
- Cai, D.; Zhu, C.; Chen, S. Microbial production of nattokinase: Current progress, challenge and prospect. World J. Microbiol. Biotechnol. 2017, 33, 84. [Google Scholar] [CrossRef]
- Jo, H.-D.; Kwon, G.-H.; Park, J.-Y.; Cha, J.; Song, Y.-S.; Kim, J.H. Cloning and overexpression of aprE3-17 encoding the major fibrinolytic protease of Bacillus licheniformis CH 3-17. Biotechnol. Bioprocess Eng. 2011, 16, 352–359. [Google Scholar] [CrossRef]
- Weng, M.; Zheng, Z.; Bao, W.; Cai, Y.; Yin, Y.; Zou, G. Enhancement of oxidative stability of the subtilisin nattokinase by site-directed mutagenesis expressed in Escherichia coli. Biochim. Biophys. Acta (BBA)-Proteins Proteom. 2009, 1794, 1566–1572. [Google Scholar] [CrossRef]
- Jomaa, A.; Boehringer, D.; Leibundgut, M.; Ban, N. Structures of the E. coli translating ribosome with SRP and its receptor and with the translocon. Nat. Commun. 2016, 7, 10471. [Google Scholar] [CrossRef] [Green Version]
- Yin, L.-J.; Lin, H.-H.; Jiang, S.-T. Bioproperties of Potent Nattokinase from Bacillus subtilis YJ1. J. Agric. Food Chem. 2010, 58, 5737–5742. [Google Scholar] [CrossRef] [PubMed]
- Keziah, S.M.; Devi, C.S. Fibrinolytic and ACE Inhibitory Activity of Nattokinase Extracted from Bacillus subtilis VITMS 2: A Strain Isolated from Fermented Milk of Vigna unguiculata. J. Protein Chem. 2021, 40, 876–890. [Google Scholar] [CrossRef] [PubMed]
- Nakamura, T.; Yamagata, Y.; Ichishima, E. Nucleotide Sequence of the Subtilisin NAT Gene, aprN, of Bacillus subtilis (natto). Biosci. Biotechnol. Biochem. 1992, 56, 1869–1871. [Google Scholar] [CrossRef] [Green Version]
- Siddiqui, K.S.; Ertan, H.; Poljak, A.; Bridge, W.J. Evaluating Enzymatic Productivity—The Missing Link to Enzyme Utility. Int. J. Mol. Sci. 2022, 23, 6908. [Google Scholar] [CrossRef] [PubMed]
- Li, Z.; Niu, C.; Yang, X.; Zheng, F.; Liu, C.; Wang, J.; Li, Q. Enhanced acidic resistance ability and catalytic properties of Bacillus 1,3-1,4-β-glucanases by sequence alignment and surface charge engineering. Int. J. Biol. Macromol. 2021, 192, 426–434. [Google Scholar] [CrossRef]
- Zhao, T.; Li, Y.; Yuan, S.; Ye, Y.; Peng, Z.; Zhou, R.; Liu, J. Structure-Based Design of Acetolactate Synthase from Bacillus licheniformis Improved Protein Stability under Acidic Conditions. Front. Microbiol. 2020, 11, 582909. [Google Scholar] [CrossRef]
- Siddiqui, K.S. Defying the activity–stability trade-off in enzymes: Taking advantage of entropy to enhance activity and thermostability. Crit. Rev. Biotechnol. 2016, 37, 309–322. [Google Scholar] [CrossRef]
- Zhang, J.-H.; Lin, Y.; Sun, Y.-F.; Ye, Y.-R.; Zheng, S.-P.; Han, S.-Y. High-throughput screening of B factor saturation mutated Rhizomucor miehei lipase thermostability based on synthetic reaction. Enzym. Microb. Technol. 2012, 50, 325–330. [Google Scholar] [CrossRef]
- Zhou, Z.; Ma, D.; Cheng, Z. Engineering of the thermophilic nitrile hydratase from Pseudonocardia thermophila JCM3095 for large-scale nicotinamide production based on sequence-activity relationships. Int. J. Biol. Macromol. 2021, 191, 775–782. [Google Scholar] [CrossRef]
- Weng, M.; Deng, X.; Bao, W.; Zhu, L.; Wu, J.; Cai, Y.; Jia, Y.; Zheng, Z.; Zou, G. Improving the activity of the subtilisin nattokinase by site-directed mutagenesis and molecular dynamics simulation. Biochem. Biophys. Res. Commun. 2015, 465, 580–586. [Google Scholar] [CrossRef]
- Liu, Z.; Zhao, H.; Han, L.; Cui, W.; Zhou, L.; Zhou, Z. Improvement of the acid resistance, catalytic efficiency, and thermostability of nattokinase by multisite-directed mutagenesis. Biotechnol. Bioeng. 2019, 116, 1833–1843. [Google Scholar] [CrossRef] [PubMed]

| A Glycerol (%) | B K2HPO4:KH2PO4 | C MnSO4 (mol/L) | D CaCl2 (g/L) | |
|---|---|---|---|---|
| 1 | 0 | 0.1 | 10−3 | 0.2 |
| 2 | 0.2 | 0.2 | 10−4 | 0.3 |
| 3 | 0.4 | 0.3 | 10−5 | 0.4 |
| No. | Variable | Nattokinase Yield (U/mL) | |||
|---|---|---|---|---|---|
| A: Glycerol (%) | B: K2HPO4:KH2PO4 (g/L) | C: MnSO4 (mol/L) | D: CaCl2 (g/L) | ||
| 1 | A1 | B1 | C1 | D1 | 541.28 |
| 2 | A1 | B2 | C2 | D2 | 240.84 |
| 3 | A1 | B3 | C3 | D3 | 931.81 |
| 4 | A2 | B1 | C2 | D3 | 484.80 |
| 5 | A2 | B2 | C3 | D1 | 619.29 |
| 6 | A2 | B3 | C1 | D2 | 234.17 |
| 7 | A3 | B1 | C3 | D2 | 1434.64 |
| 8 | A3 | B2 | C1 | D3 | 1030.80 |
| 9 | A3 | B3 | C2 | D1 | 512.51 |
| K1 | 571.31 | 820.24 | 602.08 | 557.69 | |
| K2 | 446.09 | 630.31 | 412.72 | 636.55 | |
| K3 | 992.65 | 481.44 | 995.25 | 815.80 | |
| R | 546.56 | 338.80 | 582.53 | 258.11 | |
| Optimal level | A3 | B1 | C3 | D2 |
| Enzyme | AprY | rAprY |
|---|---|---|
| isoelectric point | 6.97 | 6.61 |
| pKa of Asp 32 | 3.5 | <0 |
| pKa of His 64 | 7.7 | 7.8 |
| salt bridges | 52 | 51 |
| H bonds | 260 | 284 |
Publisher’s Note: MDPI stays neutral with regard to jurisdictional claims in published maps and institutional affiliations. |
© 2022 by the authors. Licensee MDPI, Basel, Switzerland. This article is an open access article distributed under the terms and conditions of the Creative Commons Attribution (CC BY) license (https://creativecommons.org/licenses/by/4.0/).
Share and Cite
Li, Y.; Tang, X.; Chen, L.; Xu, X.; Li, J. Characterization of a Nattokinase from the Newly Isolated Bile Salt-Resistant Bacillus mojavensis LY-06. Foods 2022, 11, 2403. https://doi.org/10.3390/foods11162403
Li Y, Tang X, Chen L, Xu X, Li J. Characterization of a Nattokinase from the Newly Isolated Bile Salt-Resistant Bacillus mojavensis LY-06. Foods. 2022; 11(16):2403. https://doi.org/10.3390/foods11162403
Chicago/Turabian StyleLi, Yuan, Xiyu Tang, Liangqi Chen, Xinran Xu, and Jinyao Li. 2022. "Characterization of a Nattokinase from the Newly Isolated Bile Salt-Resistant Bacillus mojavensis LY-06" Foods 11, no. 16: 2403. https://doi.org/10.3390/foods11162403
APA StyleLi, Y., Tang, X., Chen, L., Xu, X., & Li, J. (2022). Characterization of a Nattokinase from the Newly Isolated Bile Salt-Resistant Bacillus mojavensis LY-06. Foods, 11(16), 2403. https://doi.org/10.3390/foods11162403

